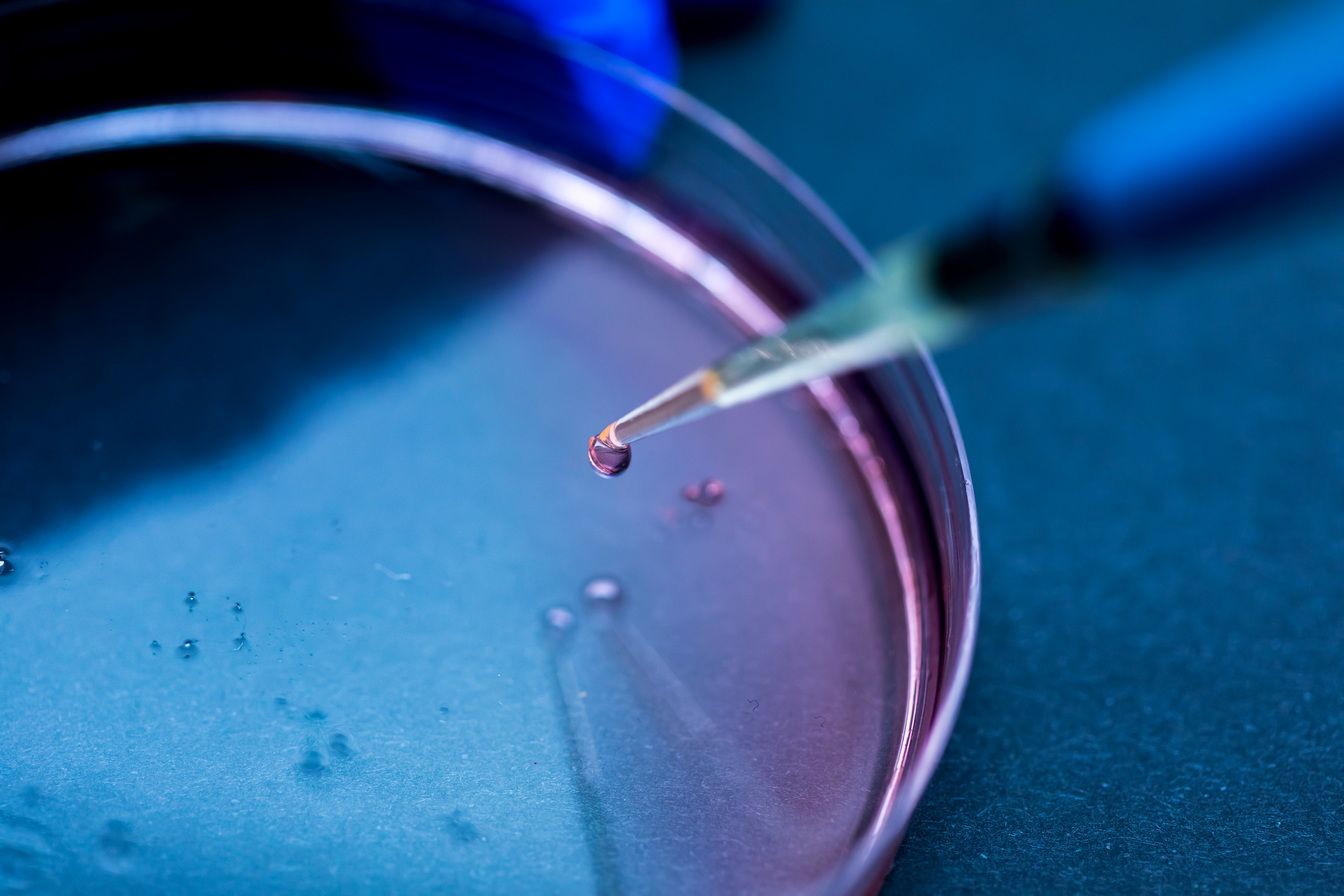
Сколько стоит донорская яйцеклетка

Сколько стоит донорская яйцеклетка
Применение донорских яйцеклеток и спермы относится к методам экстракорпорального оплодотворения (ЭКО). Благодаря этому удается выносить и родить ребенка, зачатого с помощью чужих половых клеток. Одной из главных причин применения донорских яйцеклеток является возрастное снижение фертильности. С возрастом количество и качество ооцитов у женщин снижается, а также повышается риск появления генетических аномалий, требующих применения ИКСИ и других технологий.
Что такое
донорство ооцитов
Донорство ооцитов – это передовой метод, который относится к вспомогательным репродуктивным технологиям (ВРТ), позволяет забеременеть женщинам, не способным зачать ребенка с помощью своих половых клеток. Процедура требует применения донорского материала. Полученные эмбрионы впоследствии переносят в матку пациентки.
Методику применяют при преждевременном истощении яичников (ранняя менопауза) и их недостаточном ответе на стимуляцию в протоколах ЭКО. Донорство ооцитов показано при наличии генетических заболеваний, которые могут быть переданы ребенку.
Преимущества и недостатки
донорских яйцеклеток
Донорские ооциты повышают шанс на зачатие, а также на вынашивание ребенка у пациенток, страдающих бесплодием. Методика решает эту деликатную медицинскую проблему.
Преимущества донорства ооцитов:
-
Высокая вероятность наступления беременности.
Донорские яйцеклетки получают от молодых и здоровых женщин. Это увеличивает шанс на успешное оплодотворение, имплантацию эмбриона. -
Снижение риска рождения детей с генетическими нарушениями. Методика предупреждает передачу патологии ребенку от матери, страдающей наследственными патологиями. Доноры ооцитов проходят тщательное генетическое обследование.
-
Психологический комфорт. Вынашивание ребенка позволяет установить эмоциональную связь с малышом еще во время беременности.
-
Выбор половых клеток. Пара может подбирать ооциты от женщины из каталога, учитывая данные о ее внешности, возрасте, здоровье.

Методика подходит далеко не всем семейным парам. Перед применением этого способа необходимо оценить не только его преимущества, но и недостатки:
-
Отсутствие генетической связи с ребенком. Это может быть эмоционально сложно преодолеть некоторым семейным парам. При необходимости пациентку записывают на прием к психологу, чтобы проработать имеющиеся страхи, опасения, изменить взгляд на проблему бесплодия и способы ее решения.
-
Повышение затрат. Процедура с донорскими ооцитами обходится дороже, чем ЭКО с использованием собственных яйцеклеток, так как услуга включает в себя оплату вознаграждения донору, проведение обследования, стимуляции.
-
Проведение гормональной подготовки. Пациентка проходит курс лекарственной терапии. Она повышает шансы на закрепление эмбриона, благополучное течение беременности.
-
Этические вопросы. Они связаны с анонимностью донора, правом ребенка на получение информации о своем генетическом происхождении.
Кто может стать
донором ооцитов
Доноры из базы донорства соответствуют следующим критериям:
-
Возраст. Подходят женщины в возрасте от 18 до 35 лет. Этот возраст наиболее благоприятен для сохранения фертильности.
-
Физическое здоровье. Пациентка должна быть физически здорова, не иметь хронических заболеваний, генетических нарушений, которые могут передаваться потомству.
-
Репродуктивное здоровье. Женщины, сдающие биоматериал, имеют регулярный менструальный цикл. Проблемы с репродуктивной функцией должны отсутствовать.
-
Отсутствие инфекционных заболеваний. У женщин не должно быть ВИЧ, гепатита B, C, сифилиса.
-
Отсутствие вредных привычек. Запрещены курение, прием алкоголя или наркотических веществ. Токсичные вещества могут негативно влиять на репродуктивное здоровье, провоцируя появление отклонений при развитии будущего ребенка.

Пациенты, планирующие сдачу ооцитов, проходят тщательное медицинское, генетическое обследование, а также консультацию психолога. При необходимости проводят консультации врачи других специализаций. Комплексное обследование помогает выявить показания для дополнительной диагностики, нарушения в состоянии пациентки, препятствующие сдаче здоровых половых клеток.
Как проходит процедура
Процедуру проводят врачи узкой специализации. Пациенты находятся в комфортной обстановке. Клиника оснащена всем необходимым оборудованием, которое требуется для реализации каждого этапа подготовки женщины и проведения забора ооцитов.
Этапы процедуры:
-
Консультации. Общение с пациенткой, которая хочет сдать донорские яйцеклетки. Информирование ее о ходе процедуры, возможных осложнениях.
-
Обследование. Пациентка проходит комплексную диагностику. Она включает осмотр гинеколога, анализы крови на гормоны, возможные инфекции, генетические заболевания, УЗИ.
-
Стимуляция яичников. После обследования и одобрения кандидатуры донора врачи клиники начинают гормональную терапию. Женщине вводят препараты, которые стимулируют созревание нескольких яйцеклеток одновременно.
-
Медицинское наблюдение. Во время стимуляции яичников врачи с помощью УЗИ и анализов крови контролируют изменения, происходящие в репродуктивных органах, оценивают рост фолликулов, изменяют дозу гормональных препаратов.
-
Пункция фолликулов. Когда фолликулы достигают нужного размера, то проводят их пункцию под контролем УЗИ. Яйцеклетки забирают из яичников с помощью тонкой иглы и замороженными доставляют в банк донорства, где их будут использовать в рамках проведения ЭКО. Пункция фолликулов проводится под внутривенной анестезией. Пациентка не чувствует боли, дискомфорта, легко переносит процедуру.
-
Восстановление после процедуры. После пункции фолликулов рекомендуется отдохнуть, избегая стресса, психоэмоционального напряжения, физических нагрузок. Врач может назначать поддерживающую терапию для профилактики синдрома гиперстимуляции яичников.
Стоимость
донорской яйцеклетки
Цены на донорские яйцеклетки могут отличаться в разных клиниках ЭКО. На стоимость влияет уровень медицинского учреждения, применяемые протоколы лечения, а также квалификация специалистов. В среднем цена находится в пределах 150–300 тысяч рублей и выше. Эта стоимость включает в себя оплату услуг донора, его обследование, стимуляцию, пункцию фолликулов.
Размер вознаграждения
Размер вознаграждения зависит от клиники, региона, опыта донора, конкретных требований семейной пары. В России стоимость донорства составляет 60 000-150 000 рублей. Вознаграждение платят донору после пункции фолликулов и получения яйцеклеток.
Необходимо проконсультироваться с врачом-репродуктологом или психологом, чтобы получить информацию о процедуре, ее возможных рисках, правовых аспектах.
Преимущества клиники NGC
В нашей клинике во Владивостоке действуют программы, которые проводят в рамках лечения бесплодия. Врачи применяют проверенные методы вспомогательной репродукции, проявляют деликатность и профессионализм.


